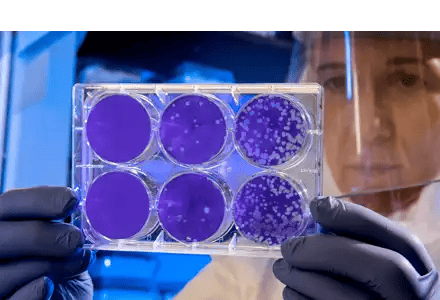
GRI-Bio_KeyImages-4

GRI Bio, Inc. (Nasdaq CM: GRI) is a pharmaceutical company specializing in developing treatments for inflammatory, fibrotic, and autoimmune diseases using Natural Killer T (NKT) cell modulators. Their strategic approach consists of a lead program entering Phase 2 for Idiopathic Pulmonary Fibrosis (IPF), a second program targeting Systemic Lupus Erythematosus (SLE), and additional early-phase development programs.
Nasdaq CM: GRI
IR Website: https://gribio.com/investors/
Nasdaq Profile: https://www.nasdaq.com/market-activity/stocks/gri
Headquarters: La Jolla, California
The leadership team is filled with industry experts, including CEO Marc Hertz, Ph.D., with extensive executive, operational, and R&D experience in the biotech industry, CSO Vipin Kumar, Ph.D., an internationally renowned NKT cell researcher, and CMO Albert Agro, Ph.D., bringing a successful track record of 20 + years in drug development.
TALK TO MANAGEMENT
GRI Bio is always available to talk to current and potential investors. They're happy to answer any questions you may have and tell you what makes their story unique. Please fill out this form, and we will connect you shortly.
GRI Bio At A Glance

GRI Bio's technology and approach focus on targeting the early drivers of inflammation, offering the potential for disease interruption and progression control. Leveraging selective immunomodulation by regulating NKT cells gives them a competitive advantage in treating inflammatory and fibrotic conditions. Their pipeline is further strengthened by a library of over 500 proprietary compounds.
A significant market opportunity lies in IPF, an orphan indication with around 40,000 new diagnoses annually, and SLE, a high-need area with limited treatment options. With promising compounds and a solid foundation for growth, GRI Bio stands at a critical juncture in areas of unmet medical need.
Key Considerations:
Targeting Immune Cells Called NKT Cells
GRI Bio's drugs act on NKT cells in the immune system to "reset" faulty immune responses that drive fibrotic and autoimmune diseases. This novel approach acts earlier in the so-called inflammatory cascade than other medicines and may therefore prove to be more effective and efficient.
Drug Entering Mid-Stage Trials for Rare Lung Disease
GRI Bio's first medicine, GRI-0621, an NKT antagonist program, has commenced patient enrollment in a Phase 2a Biomarker Study for a rare progressive lung disease called idiopathic pulmonary fibrosis (IPF). Topline interim data is expected in H1 2024.
Press Releases & Media Coverage
Social Media Updates

Recent LinkedIn Posts
Recent Facebook, Instagram, and X Posts
Investor Presentation


To download the GRI Bio, Inc. investor presentation, please fill out the form below.
Stock Chart (Intraday)
Stock Chart (Historical)
Stock Detail
The Science of NKT Cells

The science of NKT cells is complex, but it opens new doors for treating diseases driven by overzealous immune responses. In the future, NKT modulators, described below, may offer targeted immune regulation to control inflammatory diseases while avoiding the debilitating side effects of current therapies.
The immune system is your body's defense against germs and other harmful invaders. It comprises different types of cells that work together to protect you. The immune system has two main branches: the innate immune system and the adaptive immune system.
The innate immune system is your first line of defense. It responds quickly to danger signals in the body. Cells in the innate immune system include eosinophils, neutrophils, basophils, macrophages, natural killer (NK) cells, and dendritic cells (DCs). These cells patrol the body and react fast when they sense something that doesn't belong, like bacteria or viruses. They release chemicals to kill germs and attract other immune cells to help fight. This innate response isn't targeted at a specific invader - it's a more general reaction to anything the body sees as foreign or dangerous.
The adaptive immune system starts up after the innate response. It reacts more slowly but is highly specialized. The main cells are T cells and B cells. These cells are born with receptors that recognize specific molecules (antigens) on germs if those germs invade the body. They keep a record of these germs so they can more quickly attack the germs if they invade again. This immune memory is why you typically don't get diseases like chickenpox more than once.

Source: Company Documents
T cells and B cells are like soldiers gathering intelligence about invading germs. T cells directly kill infected cells in the body. B cells make antibodies that stick to specific molecules on germs, marking them for destruction. Different T cells and antibodies target specific molecules called antigens on the germ surface. Antigens can be proteins, sugars, fats, or other molecules. This specificity allows the adaptive immune system to tailor its attack to the particular germ.
The innate and adaptive immune systems work together to mount an overall defense. Specific cells act as messengers between the two systems. One important go-between is the dendritic cell. Dendritic cells consume germs and show pieces of them to T cells. This process alerts the adaptive response to signal the body which enemy has invaded.
Natural Killer T cells (NKT cells) are another type of cell that bridges the innate and adaptive immune responses. They have properties of both T cells and NK cells. Two main types are called type 1 invariant NKT (iNKT) cells and type 2 NKT cells. These cells patrol the body like sentries, looking for damaged or infected cells.

Source: Company Documents
When NKT cells spot trouble, they sound the alarm to other immune cells. They regulate the activity of dendritic cells, macrophages, T cells, B cells, and more. NKT cells also secrete chemicals that cause inflammation and direct immune responses, which helps control infection.
NKT cells normally help regulate immune responses and maintain tissue homeostasis. However, in certain diseases, NKT cells become overactivated and drive pathological inflammation. This chronic inflammation induces tissue damage and activates fibrosis, the formation of excess fibrous connective tissue that can destroy normal organ architecture. Such NKT cell-mediated inflammation and fibrosis underlie many fibrotic diseases like pulmonary, hepatic, and renal fibrosis.
Drugs that modulate NKT cell activity aim to calm this immune overreaction. They can "reset" faulty immune responses to restore a normal balance. Blocking signals from iNKT cells and stimulating type 2 NKT cells sends signals to dampen inflammation. This selective immune modulation targets the underlying issues driving disease.
By modulating the activation of NKT cells, GRI Bio aims to curb harmful inflammation, halt fibrosis progression, promote tissue repair, and restore organ function in these devastating fibrotic diseases. While the current focus is on fibrotic diseases representing major unmet needs, GRI Bio is also advancing an NKT cell therapy for autoimmune lupus into clinical development.
Overall, GRI Bio is leveraging the central regulatory effects of NKT cells to control aberrant immune responses in both fibrotic and autoimmune conditions. The goal is to develop more precise immunomodulators that reset the immune rheostat to turn down inflammation. This approach can potentially interrupt disease progression and avoid widespread immune suppression.
The GRI Bio Competitive Advantage

Treating Fibrosis: GRI Bio’s Novel Approach
Fibrosis is characterized by excessive scarring that destroys normal organ architecture. It occurs when repeated injury activates chronic inflammation, causing fibroblasts to proliferate and deposit collagen. Organs like the lungs, liver, and kidneys progressively scar until organ failure occurs.
Current anti-fibrotics like nintedanib and pirfenidone only help slow fibrosis progression in some patients. But they do not halt or reverse the fibrotic process to restore organ function.
GRI Bio is pursuing an innovative approach to treating fibrosis by targeting natural killer T (NKT) cells – master immune cells that regulate inflammation. The company aims to develop disease-modifying fibrotic therapies by dampening NKT cell-driven inflammation early in the cascade.
 Source: Company Documents
Source: Company Documents
How Fibrosis Progresses
Fibrosis starts when an initial injury triggers acute inflammation meant to heal damaged tissue. But prolonged, repeated injury causes chronic inflammation and ongoing fibrosis.
Various immune cells drive this chronic response. Activated NKT cells promote fibrotic signals like IL-13, IL-17A, and TGF-b. Macrophages and eosinophils ramp up inflammation. Fibroblasts proliferate and deposit excess collagen.
Over time, collagen accumulation destroys the normal parenchymal architecture, replacing functional tissue with non-functional scar tissue. As scarring worsens, it further stokes chronic inflammation, fueling more fibroblast activation and collagen deposition. This feedback loop leads to progressive, irreversible organ damage.
GRI Bio’s Potential Advantage
Current anti-fibrotic drugs only help slow fibrosis progression in some patients. But they do not interrupt the actual fibrotic process to achieve disease modification.
By targeting NKT cells upstream, GRI Bio aims to broadly dampen multiple downstream fibrotic pathways. This strategy could halt fibrosis, restore organ function, and not just slow decline.
In preclinical models of lung, liver, and kidney fibrosis, GRI Bio’s NKT inhibitors reduced inflammatory cell infiltration, cytokine production, and collagen deposition, preventing progressive scarring.
Moving to the Clinic
GRI Bio’s lead NKT inhibitor, GRI-0621, significantly decreased fibrosis in animal models of lung, kidney, and liver disease. The company is now advancing GRI-0621 into Phase 2 studies for idiopathic pulmonary fibrosis. Positive results could support advancing it as a first-in-class anti-fibrotic in additional fibrotic diseases.
By leveraging NKT cells’ central regulatory effects, GRI Bio aims to control runaway inflammation and fibrosis in multiple organs. Targeting these master immune cells represents an exciting new therapeutic approach in fibrotic disease.
For an overview of GRI Bio's competitive advantage, please watch the following one-minute video:
Source: Company Documents
iNKT: Mechanism of Action

How iNKT Cells Drive Tissue Fibrosis
Fibrosis is excessive scarring that can damage organs like the lungs, liver, and kidneys. It often results from chronic inflammation driven by immune cells called invariant Natural Killer T (iNKT) cells. Here’s a step-by-step look at how iNKT cells spark this harmful tissue fibrosis.
-
Tissue Injury Occurs. First, some kind of harm or infection causes injury to cells in the organ. This injury could be a bacterial infection in the lung, toxins that damage liver cells, or an autoimmune attack on kidney tissue. The injured cells release chemical warning signals called alarmins to notify the immune system of something wrong.
-
iNKT Cells Get Activated. iNKT cells constantly survey for signs of cell damage. When they detect alarmins and other danger signals, they become activated. Activated iNKT cells start secreting pro-inflammatory cytokines like IL-17A, IFNγ, and TNFα. These are chemical messenger proteins that ramp up inflammation.
-
Recruitment of Other Immune Cells. The cytokines released by iNKT cells call other immune cells to the injury site. Neutrophils and eosinophils arrive first and release reactive oxygen species, further damaging tissue. Monocytes enter and mature into macrophages. Immune cells release more signaling chemicals like IL-6 and IL-1β that turn up the inflammation.
-
Tissue-Damaging Inflammation Inflammatory chemicals like IL-17A and IL-6 switch on T helper 17 (Th17) cells. These are a subtype of T cells that secrete more IL-17A, keeping inflammation blazing. B cells start pumping out autoantibodies that tag healthy tissue as foreign to the immune system. Clogged with immune cells, the area becomes inflamed. This swelling and inflammation harms healthy tissue.
-
Fibroblast Activation. While all this immune activity damages tissue, it also stimulates local connective tissue cells called fibroblasts. Activated fibroblasts start proliferating and secreting collagen, which forms stiff scar tissue. They also release proteins like periostin that further drive fibrosis.
-
Scarring and Fibrosis. As collagen deposits build up, scars expand, and organ architecture becomes distorted. The organ may be permanently scarred, preventing normal function. For example, lung fibrosis obstructs oxygen exchange. Liver fibrosis disrupts blood flow and metabolism. Kidney fibrosis causes dangerous protein loss. The cycle reinforces itself as tissue scarring spurs more inflammation.
Source: Company Documents
Therapies that block iNKT cells aim to reduce harmful inflammation and fibrosis by interrupting this process near the start. Acting earlier prevents downstream immune cell involvement and tissue scarring. It’s like turning down a dimmer switch to dampen the overall inflammatory cascade before it spirals out of control.
Targeting iNKT cells higher up may offer advantages over therapies directed at single downstream factors like IL-17A or T cells. Hitting one branch of inflammation typically allows other arms to continue driving disease. Acting at a master immune junction point like iNKT cells provides more complete control over the complex inflammatory network.
However, we still have much to learn about targeting iNKT cells for inflammatory disorders. Clinical research will uncover benefits, limits, and optimal applications of this approach. But modulation of these central immune cells holds promise for simultaneously resetting multiple out-of-whack immune pathways. Overall, therapies inhibiting iNKT cells could offer a new angle of attack for hindering harmful inflammation and fibrosis in chronically damaged organs.
For an overview of iNKT cells, please watch the following one-minute video:
Source: Company Documents
A Large Development Pipeline and a Library of 500+ Compounds

GRI Bio is building a differentiated pipeline of novel immunotherapies leveraging its expertise in natural killer T (NKT) cell biology. The company’s lead programs target underserved patient populations across inflammatory, fibrotic, and autoimmune disorders.
GRI-0621 for Idiopathic Pulmonary Fibrosis
The lead program, GRI-0621, is an oral inhibitor of type 1 invariant NKT (iNKT) cells being developed for idiopathic pulmonary fibrosis (IPF). IPF is a chronic, progressive fibrotic disease affecting the lungs and impacting around 40,000 new patients annually in the US. It has a poor prognosis, with a median survival of only 2-3 years after diagnosis.
Despite the high unmet need, there are only two approved IPF therapies, both of which have significant tolerability issues and no survival benefit. GRI-0621 aims to address this by selectively inhibiting iNKT cells, a key driver of lung fibrosis progression. By acting upstream to block damaging inflammatory and fibrotic processes, GRI-0621 could slow or halt IPF disease progression. Its novel mechanism of iNKT inhibition differentiates it from competitors.
GRI-0621 commenced patient enrollment in a Phase 2a biomarker study in IPF patients in 2023. Interim data are expected in the first half of 2024, and topline data in the second half of 2024. Positive results would validate the inhibition of iNKT cells as a promising new approach in IPF.
GRI-0803 for Systemic Lupus Erythematosus
The second program, GRI-0803, is an oral type 2 NKT cell agonist initially being developed for systemic lupus erythematosus (SLE). SLE is a chronic autoimmune disorder affecting approximately 160,000 patients in which the immune system attacks healthy tissue and organs.
Current SLE therapies are limited to broadly immunosuppressive drugs and steroids, which provide only temporary symptom relief and have toxicities. GRI-0803 aims to treat SLE by precisely tuning faulty immune responses using the body’s natural brakes called type 2 NKT cells. GRI-0803 demonstrated the ability to improve kidney inflammation and damage in SLE models. The company plans to file an IND in 2024 to start first-in-human testing, with initial Phase 1 data expected by the end of 2024.
GRI-0124 for Primary Sclerosing Cholangitis
GRI-0124 is an oral Type 2 NKT agonist reformulation of an approved drug that will be developed for primary sclerosing cholangitis (PSC) using a 505(b)(2) regulatory pathway. PSC is a rare progressive liver disease impacting approximately 42,000 patients in the US. The 505(b)(2) pathway allows partial reliance on existing safety and efficacy data, enabling a more efficient development path. GRI-0124 could address the exceptionally high unmet need for this neglected orphan disease.
Additional Undisclosed Program
GRI Bio is also developing an additional undisclosed NKT agonist program. While details remain confidential, the company hints it is for a high-value autoimmune indication with sizeable commercial potential.
Robust Discovery Platform
Supporting these programs is GRI’s strong discovery engine, with a library of over 500 proprietary compounds tailor-made to modulate NKT cell subtypes. This diverse pipeline-fueling platform establishes the company as a leader in NKT biology and enables the pursuit of best-in-class therapeutics across a spectrum of immune disorders.
GRI Bio’s burgeoning pipeline exemplifies its leadership in the emerging field of NKT cell modulation. The company is leveraging novel NKT agonists and inhibitors to address inflammatory diseases with major unmet needs.
The seasoned management team has demonstrated drug development and commercialization expertise, attracting seasoned investors. With clinical catalysts approaching in 2024, GRI Bio is poised to potentially deliver transformative new therapies to patients underserved by current options.
The development pipeline targeting IPF, SLE, and other high-value indications highlights the promise of GRI’s NKT-targeting approach. Successful demonstration of clinical proof-of-concept for modulation of NKT cell subtypes would solidify GRI Bio as a trailblazer in next-generation immunology-focused medicine.
GRI-0621 - New Hope for a Deadly Lung Disease

Source: Company Documents
Idiopathic pulmonary fibrosis, or IPF, is a rare chronic lung disease without a cure. It causes progressive scarring of the lungs, making it hard to breathe. Half of the patients die within three years of diagnosis. But a new drug called GRI-0621 brings fresh hope for treating this devastating illness.
What is IPF?
IPF is a mysterious disease where lung tissue becomes thickened and stiff over time. Normally, the lungs are stretchy and springy to expand with each breath. But with IPF, stiff scar tissue accumulates and blocks oxygen from reaching the bloodstream.
Doctors don't know exactly what triggers IPF to start damaging the lungs. It usually strikes people around age 60-70 with no family history of the disease. Men get IPF more often than women. At first, patients notice shortness of breath during activity as scarred areas resist stretching. But scarring keeps spreading, and soon even resting breaths become difficult. Performing daily tasks becomes a struggle. There is no cure for IPF. Half of patients die within 2-3 years of diagnosis without a lung transplant. Tragically, the average survival is only about three years after symptoms start.
Current Treatments Fall Short
Currently, only two FDA-approved drugs can slow IPF progression: pirfenidone and nintedanib. But they don't stop or reverse the steady lung damage. And they cause gastrointestinal side effects like nausea and loss of appetite. So, taking high doses consistently is difficult for many patients. Stopping the medications allows IPF to rapidly worsen again. Even with treatment, most patients gradually lose lung function over time. New options are desperately needed.

Source; Company Documents
GRI Bio Aims to Revolutionize Treatment
That's where the biotech startup GRI Bio enters the scene. GRI Bio is developing an oral drug called GRI-0621 to inhibit lung scarring in IPF. By damping down immune signals that drive fibrosis, GRI-0621 could revolutionize treatment.
GRI-0621 targets inflammatory immune cells called invariant natural killer T (iNKT) cells. Research shows that iNKT cells trigger inflammation and promote lung fibrosis after injury. By blocking these cells, GRI-0621 reduces downstream damage in IPF animal models. Now preparing for human trials, GRI-0621 offers fresh hope for IPF patients. It represents an entirely novel approach to treating this deadly fibrotic disease.
Streamlined Testing Underway
Because GRI-0621 contains an approved ingredient, an oral formulation of an FDA-approved topical dermatology product called tazarotene, GRI Bio can leverage the FDA's 505(b)(2) pathway to accelerate development. This regulatory shortcut allows some safety data from earlier studies to support new approvals. GRI Bio plans a Phase 2a biomarker trial in 36 IPF patients starting mid-2023. Patients will take GRI-0621 or placebo pills daily alongside their standard therapy. The main goal is proving GRI-0621 inhibits iNKT cells as intended. The team will also look for signs that lung scarring markers improve. But full testing for benefits awaits future large studies if all goes well.
This streamlined trial could give an early preview of GRI-0621's effects. Interim results will arrive in the first half of 2024, with final data in late 2024. Positive results would set the stage for more definitive Phase 3 testing.
A Beacon of Hope
In the IPF community, GRI-0621 provides a beacon of hope. Current options only slow progression, but GRI-0621 aims to prevent scarring that destroys the lungs directly. Turning off iNKT cells could fundamentally alter IPF's course.
Of course, many questions remain. Research must establish GRI-0621's long-term safety and efficacy. But its unique mechanism offers a tantalizing new foothold against this incurable illness. GRI Bio's work represents the vanguard of innovation that may one day make IPF a manageable condition.
For patients facing IPF's suffocating grip, the possibility of reversing damage seemed a distant dream. GRI-0621 brings that vision closer to reality. With some luck and continued research, help for this devastating disease could soon breathe new life into many.
Recent Acquisitions in IPF Bode Well for GRI Bio

GRI Bio is developing an iNKT inhibitor called GRI-0621 to treat idiopathic pulmonary fibrosis (IPF). IPF is a chronic, progressive lung disease characterized by scarring of the lungs that worsens over time. The prognosis is poor, with median survival after diagnosis ranging from 2-3 years. Limited treatment options are available, and no current drugs meaningfully improve survival.
Given the high unmet need, IPF has been an attractive area for pharmaceutical companies looking to expand their portfolios.
Recent deals include:
-
In July 2019, Galapagos and Gilead Sciences entered into a global R&D collaboration focused on IPF. As part of this, Gilead made an upfront payment of $3.96 billion to Galapagos and a $1.1 billion equity investment. Galapagos’ IPF candidate GLPG1690 was the lead asset subject to the collaboration.
-
In 2019, Roche acquired Promedior and its lead IPF asset PRM-151 for up to $1.4 billion ($390 million upfront payment). PRM-151 was in Phase 2 clinical trials.
-
In 2019, BridgeBio acquired Positron Technologies and their IPF candidate BBP-265 for up to $505 million ($50 million upfront, $455 million in milestones). BBP-265 was in preclinical development.
-
In 2020, Redx Pharma licensed their IPF candidate RXC004 to AstraZeneca. The deal was worth up to $17 million ($2.5 million upfront payment). RXC004 was also preclinical.
-
In 2020, Daix Biopharm (the API venture of Dong-A Socio Holdings) acquired DHS Therapeutics and their preclinical monoclonal antibody DHS 101 for IPF for $20 million upfront.
-
In 2021, Morphogen-IX and Graviton Therapeutics merged to form Morphi Therapeutics, financed by a $4 million initial investment. Both companies had preclinical IPF programs.
These deals have several implications for GRI Bio:
First, they demonstrate that IPF remains an attractive area for business development, with five acquisitions of early-stage assets over the past three years.
Second, they show that pharmas are willing to pay substantial upfronts and milestones even for preclinical IPF assets. The $50 million upfront BridgeBio received underscores the value of novel mechanisms like GRI-0621.
Third, they provide valuation benchmarks that GRI Bio could reference in partnering negotiations once they have Phase 2a data for GRI-0621 in 2024. The up to $505 million deal for preclinical BBP-265 gives a sense of the potential value.
Finally, they signal a dynamic and competitive IPF space, where firms are actively consolidating to build critical mass. This recent surge in acquisitions bodes well for GRI Bio’s ability to attract partners if GRI-0621 shows promising clinical activity.
In summary, the IPF acquisitions (shown below) validate pharmaceutical interest in the space, demonstrate their willingness to pay significant upfronts for early programs, and suggests GRI-0621 could command material economics if Phase 2 data looks positive. The deals highlight the potential significant upside for GRI Bio in IPF.

Source: Company Documents
GRI-0803: A New Treatment of Systemic Lupus Erythematosus (SLE)

Source: Company Documents
GRI Bio is developing novel therapies that modulate natural killer T (NKT) cells to treat autoimmune and inflammatory diseases. The company’s lead preclinical asset in that effort is GRI-0803, a type 2 NKT agonist initially being developed for systemic lupus erythematosus (SLE).
GRI-0803 is a small molecule drug that activates type 2 NKT cells, an immune cell subtype involved in regulating inflammation. Specifically, GRI-0803 binds to and activates type 2 NKT cells by interacting with proteins on their surface. By selectively activating type 2 NKT cells, GRI-0803 can dampen inflammatory responses and potentially resolve autoimmune reactions in diseases like SLE. The goal is to precisely tune faulty immune responses back to a normal state.
GRI-0803 represents a new approach to treating autoimmunity compared to broadly immunosuppressive therapies like chemotherapy drugs, steroids, or anti-inflammatory biologics. Those therapies suppress large portions of the immune system, often leading to significant side effects. In contrast, GRI-0803 aims to act more specifically by activating the immune system’s natural brakes provided by type 2 NKT cells.
The initial focus for GRI-0803 is on SLE, also known as lupus, a chronic and potentially fatal autoimmune disease that affects approximately 160,000 Americans. It is nine times more common in women than men. In SLE, the immune system mistakenly attacks the body’s own healthy tissues and organs, including the skin, joints, kidneys, brain, heart, and lungs. This action leads to widespread inflammation and damage that can be severe or even life-threatening.
Source: Company Documents
There is a significant unmet need for new SLE therapies. Current treatments like chemotherapy, steroids, and anti-inflammatory biologics can have serious side effects and only provide symptom relief rather than treating underlying disease drivers.
Animal model data suggests GRI-0803 may inhibit kidney inflammation and damage associated with SLE. Kidney involvement, called lupus nephritis, is a frequent complication and a leading cause of morbidity in SLE patients. By reducing harmful immune reactions in the kidneys, GRI-0803 could potentially prevent irreversible organ damage and improve long-term outcomes.
GRI has extensive intellectual property (IP) protection for GRI-0803, including issued composition of matter and use patents. This means they have patents covering the compound itself as well as methods of using it to treat particular diseases.
GRI Bio indicates they expect to have exclusivity and patent protection for GRI-0803 extending out until at least 2038. Robust IP coverage is crucial because it prevents competitors from duplicating GRI’s work or developing the same drug. Strong IP fortifies GRI’s competitive positioning in SLE and maximizes its optionality in partnering or licensing discussions.
Upcoming Milestones
GRI Bio is progressing GRI-0803 through preclinical development and plans to submit an Investigational New Drug (IND) application in the first half of 2024. The IND is the necessary regulatory step to begin testing the drug in human patients. Once the IND is approved, GRI plans to start a Phase 1a/1b clinical trial in SLE patients to evaluate the safety, tolerability, and initial efficacy of GRI-0803. The hope is that the Phase 1 data will show GRI-0803 is well-tolerated while providing early signs of disease-modifying activity.
Source: Company Documents
Topline results from the Phase 1 study are anticipated in the second half of 2024. Positive data would support continued advancement into larger Phase 2 clinical trials.
Lupus represents a substantial commercial opportunity given the sizeable patient population and high unmet need. As mentioned, SLE impacts approximately 160,000 Americans, predominantly young women. However, since the current standard of care options are limited, analysts project the SLE market will grow from $2.2 billion in 2022 to $6.5 billion in 2030. This forecasted expansion indicates there is ample room for novel therapies like GRI-0803 that can address the shortcomings of existing drugs.
Beyond SLE, GRI Bio believes type 2 NKT agonists like GRI-0803 may have potential in other autoimmune diseases that collectively impact millions of patients worldwide. These include rheumatoid arthritis, multiple sclerosis, inflammatory bowel disease, and type 1 diabetes.
Entering some of these larger indications could drastically increase the commercial prospects for the platform. GRI Bio’s presentation lists a range of autoimmune disorders with patient populations spanning from 200,000 to 3 million patients in the United States alone.
The market opportunity is significant. By precisely activating type 2 NKT cells, GRI’s investigational new drug GRI-0803 offers a targeted immunomodulatory approach to treating SLE and other autoimmune disorders. The company has strong IP coverage extending through 2038 and plans to file an IND application in 2024 to begin first-in-human clinical studies. Initial data from the Phase 1 trial is expected by late 2024. With lupus representing a $6.5 billion opportunity and expansion possibilities into other inflammatory diseases, GRI-0803 has blockbuster potential if the early clinical results look promising. Its unique mechanism of action and focus on under served autoimmune patients sets it apart from competing therapies. GRI-0803 exemplifies the company’s commitment to advancing innovative NKT-targeting medicines for patients suffering from dysregulated immune responses and inflammation.
A Pipeline of Expansion Opportunities in Autoimmune Diseases

GRI Bio is developing novel immunotherapies that modulate natural killer T (NKT) cells to treat inflammatory and autoimmune disorders. While the company’s lead preclinical asset, GRI-0803, is initially focused on systemic lupus erythematosus (SLE), GRI sees substantial pipeline expansion potential in other autoimmune diseases.

Source: Company Documents
Specifically, there are large patient populations across five autoimmune conditions that could be future opportunities for its type 2 NKT agonist platform:
Multiple Sclerosis (MS). MS is an autoimmune condition in which the immune system attacks the myelin sheaths that insulate nerve fibers. This attack leads to neurological impairment, disability, and reduced quality of life. Around 1 million adults in the US have MS. Worldwide, nearly 3 million individuals suffer from this chronic neurodegenerative disease. Current MS therapies reduce the frequency of inflammatory flares but do not address the underlying autoimmunity. They also carry significant safety risks like brain infections. By damping aberrant immune responses, GRI’s type 2 NKT agonists could provide a novel approach to treating MS and preventing neurological damage.
Rheumatoid Arthritis (RA). RA is an autoimmune disorder characterized by painful inflammation and progressive joint destruction. It affects over 1.5 million Americans. Current RA treatments like DMARDs, biologics, and JAK inhibitors reduce symptoms but have limitations in efficacy and side effects. RA involves multiple immune pathways, including overactive T cells, B cells, macrophages, and fibroblast-like cells called synoviocytes. GRI’s NKT modulators could potentially rebalance immunity and inhibit joint inflammation and damage in RA.
Inflammatory Bowel Disease (IBD). IBD refers to chronic inflammatory conditions like Crohn’s disease and ulcerative colitis impacting the gastrointestinal tract. IBD afflicts around 1.6 million people in the United States. It can severely impair the quality of life. Existing IBD therapies like steroids, immunosuppressants, and TNFa inhibitors have limited efficacy and durability. Early preclinical data suggests GRI’s type 2 NKT agonists reduce inflammation in mouse models of colitis, supporting study in IBD.
Type 1 Diabetes Mellitus (T1DM). T1DM is an autoimmune disorder in which immune cells attack and destroy the insulin-producing beta cells in the pancreas. Around 200,000 Americans have T1DM, an incurable lifelong condition requiring insulin treatment. Islet cell transplantation is an experimental treatment option with challenges like limited organ supply. GRI’s NKT agonists could potentially rebalance immunity and preserve remaining beta cell mass in T1DM patients.
Amyotrophic Lateral Sclerosis (ALS). ALS, also called Lou Gehrig’s disease, is a neurodegenerative autoimmune condition causing disabling muscle weakness. An estimated 20,000 Americans have ALS. It is uniformly fatal, usually within 2-5 years of diagnosis. The only two FDA-approved ALS therapies provide marginal efficacy benefits. NKT cell modulation represents an emerging target for halting neuroinflammation and motor neuron damage in ALS.
In preclinical studies, GRI’s type 2 NKT agonists showed promising anti-inflammatory effects in animal models across these five autoimmune diseases. The large patient populations – from 20,000 to 3 million in the US alone – underscore the substantial commercial potential.
The NKT platform’s unique ability to selectively dampen autoimmunity could address shortcomings of current therapies like limited efficacy and systemic toxicity. The pipeline expansion opportunities in MS, RA, IBD, T1DM, and ALS highlight the breadth of possibilities for the company to pursue, both independently and in collaboration with partners.
While still early, GRI Bio’s immunotherapy approach appears well-suited for various immune-driven conditions with high unmet needs. The initial focus on SLE provides a beachhead to demonstrate the platform’s capabilities. But the ultimate scope of the pipeline could reach far beyond that, with drug candidates tailored to the immunopathology of each disease.
Advancing the NKT agenda across multiple autoimmune indications would strategically diversify GRI’s portfolio while positioning the company as an emerging leader in high-value immunology. The pipeline expansion opportunities in MS, RA, IBD, T1DM, and ALS underscore the potential of the company’s novel science to help millions of patients struggling with immune dysfunction and inflammation.
A Summary of Upcoming Milestones

GRI Bio is an emerging biotechnology company developing novel immunotherapies targeting dysregulated immune responses. The company has outlined multiple upcoming milestones spanning its clinical programs and corporate operations.

Source: Company Documents
For GRI-0621, an iNKT cell inhibitor for idiopathic pulmonary fibrosis (IPF), key milestones include:
-
Launching a Phase 2a biomarker study in IPF patients in the second half of 2023. This phase successfully evaluated GRI-0621’s ability to inhibit iNKT cells and related anti-fibrotic effects.
-
Reporting interim data from the Phase 2a study in the first half of 2024. The interim analysis will provide an early read on safety, biomarker inhibition, and potential positive signals on lung function.
-
Announcing topline results from the Phase 2a trial in the second half of 2024. The full dataset will assess GRI-0621’s impact on iNKT cell inhibition and fibrosis-related biomarkers after 12 weeks of treatment.
These Phase 2a milestones will provide critical proof-of-concept data on GRI-0621’s effects on iNKT biology and potential anti-fibrotic activity. Positive results would support continued advancement into larger Phase 2b studies.
For GRI-0803, a type 2 NKT agonist initially for systemic lupus erythematosus (SLE), key upcoming milestones are:
-
Completion of preclinical studies and filing of an IND in the first half of 2024 to start first-in-human clinical trials. IND clearance from the FDA will allow the evaluation of GRI-0803 in SLE patients.
-
Initiating a Phase 1a/1b study in SLE patients in 2024 after IND approval. The Phase 1 trial will assess safety, tolerability, pharmacokinetics, pharmacodynamics, and early efficacy signals.
-
Reporting topline data from the Phase 1 study in the second half of 2024. Results will inform the optimal dosing and enable the selection of endpoints for future Phase 2 testing.
These Phase 1 milestones will mark GRI-0803’s clinical debut and provide early insight into its therapeutic potential in SLE. The Phase 1 readout could highlight expansion opportunities beyond SLE into larger autoimmune populations.
At the corporate level, GRI Bio has one major upcoming milestone:
-
Raising additional capital through the combined company to fund operations and pipeline advancement. The financing is expected to provide runway through multiple value-driving catalysts in 2024.
GRI Bio has a slate of upcoming clinical, regulatory, and corporate milestones over the next 18 months. The Phase 2a data for GRI-0621 and initial Phase 1 results for GRI-0803 will provide important clinical validation for the company’s NKT modulation platform. Achieving these collective milestones will help elevate GRI Bio’s status as an emerging biotech leader developing innovative immunology therapies.
An Exceptional and Experienced Management Team

Source: Company Documents
Marc Hertz, Ph.D. - PRESIDENT, CHIEF EXECUTIVE OFFICER AND DIRECTOR
Dr. Hertz has over 20+ years of executive, operational, and R&D experience in the biotech industry. He has an outstanding track record of developing novel therapeutics from concept to the clinic, including DNA-based therapeutics, peptides, biologics, and small molecules. Previously, Dr. Hertz co-founded and served as Chief Executive Officer of Multimeric Biotherapeutics and as Chief Executive Officer of Pharmexa, Inc., the US subsidiary of Pharmexa A/S [CSE:PHARMX]. Dr. Hertz has served on the Board of Directors for GemVax A/S, Multimeric Biotherapeutics, and Evozym Biologics. Dr. Hertz’s therapeutic expertise includes immune tolerance, autoimmunity, allergy, oncology, inflammation, and fibrosis. He received his undergraduate biology degree from Bowdoin College and his doctoral degree in immunology and microbiology from the University of Colorado Medical School.
Vipin Kumar Chaturvedi, Ph.D. - CHIEF SCIENTIFIC OFFICER
Dr. Chaturvedi co-founded GRI in 2009 and, since its inception, has served as a member of its board of directors and as Chairman of its scientific advisory board. Dr. Chaturvedi served as GRI’s Chief Scientific Officer from 2009 to 2017 and reassumed the role in 2022. Dr. Chaturvedi has served as a Professor of Medicine, Laboratory of Immune Regulation at the University of California, San Diego, since April 2015. In 2015, Dr. Chaturvedi co-founded Simomics, UK, a simulation software company, and served as a non-executive director from 2015 to July 2022. Additionally, Dr. Chaturvedi has served on the board of directors of Vidur Discoveries, LLC, a consulting company, since 2009. Dr. Chaturvedi obtained his undergraduate degree in biology from the Kanpur University, India, his master's in biochemistry, molecular biology, and immunology from the Institute of Medical Education & Research, India, and his Ph.D. in biochemistry from the Indian Institute of Science India.
Albert Agro, Ph.D. - CHIEF MEDICAL OFFICER
Dr. Agro co-founded GRI in 2009 and has served as a consultant to GRI with the title of Chief Medical Officer since August 2017. Dr. Agro has served as President and Chief Executive Officer of Columbia Therapeutics Inc. since April 2021 and has over 20 years of experience in the biotechnology and pharmaceutical industries, having held several senior clinical and development positions, including Chief Executive Officer of Sublimity Therapeutics Inc. from March 2018 to April 2021 and Chief Medical Officer at Cynapsus from June 2012 to September 2016. Additionally, Dr. Agro currently serves as an assistant professor in the Department of Pathology and Molecular Medicine at McMaster University. Dr. Agro received in Ph.D. in immunology from the Department of Medicine at McMaster University.
Leanne Kelly - CHIEF FINANCIAL OFFICER
Ms. Kelly has served as GRI Bio’s Chief Financial Officer since April 2023. She brings over 20 years of experience leading private and publicly traded companies across life science, technology, and e-Commerce sectors with a foundation in public accounting. Before joining GRI Bio, she most recently served as Chief Financial Officer of Vallon Pharmaceuticals from May 2021 until April 2023. Earlier, she was Controller and Executive Director, Global Financial Reporting at OptiNose, Inc. from 2016 to 2021. Throughout her career, she has held Senior Vice President of Finance, Controller, and Chief Financial Officer positions in private and public companies such as Flower Orthopedics from 2013 to 2016, Iroko Pharmaceuticals, LLC in 2013, and Genaera Corporation from 2002 to 2009. Ms. Kelly received her undergraduate degree in business economics with a concentration in accounting from Lehigh University and is a licensed CPA (inactive status) in the State of Pennsylvania.
SEC Filings
Financials
Risks & Disclosures

This communication is neither an offer to sell nor a solicitation of an offer to buy, nor a recommendation of any securities of the company mentioned herein.
GRI Bio, Inc. (the “Company”) has reviewed the content of this page as well as the accompanying presentation (“Company Presentation”) displayed on this page. To the best of its knowledge, the Company does not believe this content to be misleading or inaccurate in any material respect, nor does it believe there are any material omissions with respect to such content. The Company does not believe the contents of the page or the Company Presentation to contain any non-public material information.
Information and opinions presented in the Company Presentation are provided by the Company, and b2iDigital makes no representation as to their accuracy or completeness. The information contained on this page is not intended to constitute any form of advice, and the information provided is not intended to provide a sufficient basis on which to make an investment decision. It is not investment research, nor does it constitute a research recommendation, as it does not constitute substantive research or analysis. This information is not to be relied upon in substitution for the exercise of independent judgment.
Information, opinions and estimates contained on this page or in the Company Presentation reflect judgments by the Company as of the original date of publication by the Company and are subject to change without notice. Past performance should not be taken as an indication or guarantee of future performance, and no representation or warranty, express or implied is made regarding future performance.
A complete description of the risks and uncertainties relating to the Company and its securities can be found in the company's filings with the U.S. Securities and Exchange Commission available for free at www.sec.gov.
Information on this page may relate to penny stocks, which may also be referred to as low-priced stocks. Penny stocks are low-priced shares typically issued by small companies. Penny stocks involve greater than normal risk, they may be less liquid than other stocks (i.e., more difficult to sell), and there may be less reliable information available regarding such stocks. Investors in penny stocks should be prepared for the possibility that they may lose their entire investment.
b2i digital or its related entities may own securities of the Company.
The Company is a client of b2i Digital. The Company agreed to pay b2i Digital no greater than $100,000 in cash for 12 months of digital marketing consulting and investor awareness services.
This communication includes forward-looking statements that involve risks, uncertainties and assumptions that are difficult to predict. Words and expressions reflecting optimism, satisfaction or disappointment with current prospects, as well as words such as “believes,” “hopes,” “intends,” “estimates,” “expects,” “projects,” “plans,” “anticipates” and variations thereof, or the use of future tense, identify forward-looking statements, but their absence does not mean that a statement is not forward-looking. The Company’s forward-looking statements are not guarantees of performance, and actual results could vary materially from those contained in or expressed by such statements due to risks, uncertainties and other factors. The Company urges readers to consider specifically the various risk factors identified in its most recent Form 10-K, and any risk factors or cautionary statements included in any subsequent Form 10-Q or Form 8-K, filed with the SEC. Readers are cautioned not to place undue reliance on these forward-looking statements, which speak only as of the date of this communion. Except as required by law, the Company does not undertake any responsibility to update any forward-looking statements to take into account events or circumstances that occur after the date of this communication.
The GRI Bio management and investor relations team are available to talk to current and potential investors. They're happy to answer your questions and tell you what makes their story unique. Please fill out this form, and we will connect you shortly.
• Directly hear the GRI Bio story
• Ask your questions
• Submit the form below, and someone will get in touch with you as soon as possible
Note: Company management or its representative can only discuss and disclose information that is already available in the public domain. They will do their best to clarify such information to the extent permitted by securities law and industry regulations.

Targeting Fibrosis Through Innovative Science
The company’s lead Phase 2a trial of asset GRI-0621 for IPF commenced enrollment, with interim data expected in H1 2024 and topline results in H2 2024. GRI also has preclinical programs exploring fibrotic diseases like primary sclerosing cholangitis.